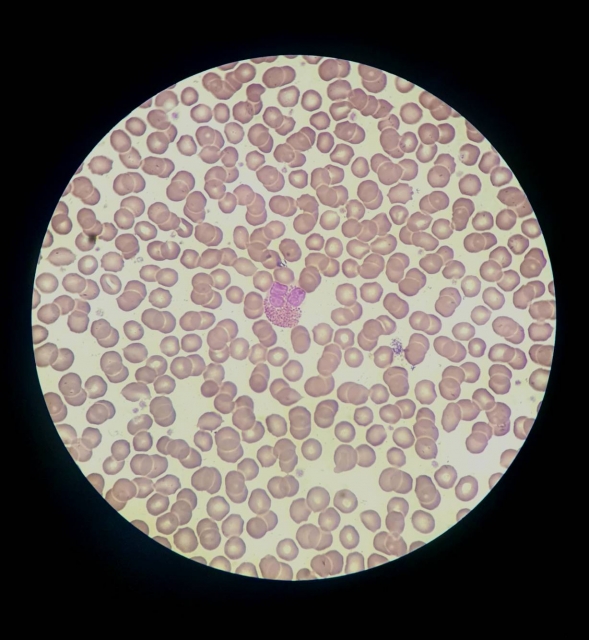
好酸球性副鼻腔炎

副鼻腔炎(蓄膿症)の記事一覧
アクセス
- クリニック名
- 医療法人社団皐八会 武田耳鼻咽喉科
- 住所・所在地
- 〒354-0018 埼玉県富士見市西みずほ台1-19-5
- 電話番号
-
049-254-8733
※電話対応は行っておりません - アクセス
- 東武東上線みずほ台駅西口、駅から徒歩1分。交番隣り。
- 駐車場
- 敷地内駐車場5台。
周辺に無料で使える提携駐車場もあり。 - 営業時間
-
午前診療:9:00 ~ 12:00
午後診療:15:00 ~ 18:00
休診日:木曜日、土日は午前診療のみ
※土曜日の午前診療は9:00 ~ 12:30です。
※日曜日の午前診療は8:30 ~ 9:30です。
武田耳鼻咽喉科では
みなさまに寄り添った診療を
心がけております。
みなさまに寄り添った診療を
心がけております。
フォームからのお問い合わせ
簡単WEB予約はこちら
当院は保険医療機関です。
保険証を持参の上、ご来院ください。
また、当院ではオンライン資格確認を推進しています。
保険証を持参の上、ご来院ください。
また、当院ではオンライン資格確認を推進しています。